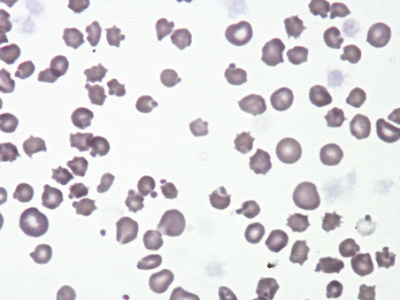
Corpos de Heinz e anemia por dano oxidativo.

Artigos
Amostra para estudo de líquido cefalorraquidiano.
Para estudo de líquido cefalorraquidiano (LCR) é necessário: LCR em tubo EDTA para contagem celular e citologia, LCR em tubo seco para medição das proteínas totais, outros parâmetros bioquímicos e serologias, LCR num 3º tubo seco, em caso de se pretender uma cultura microbiana. Deve ser ainda enviado um tubo seco com sangue para obtenção de soro, necessário na preparação da citologia.
Corpos de Heinz e anemia por dano oxidativo.
Os corpos de Heinz foram descritos pela primeira vez em 1890 como estruturas redondas em protusão na superfície dos eritrócitos de humanos e animais. Estas estruturas, que estão associadas a destruição eritrocitária, podem ser encontradas em várias espécies secundariamente a dano oxidativo. As causas mais frequentes de dano oxidativo nas espécies domésticas são a administração de acetaminofeno (Cão/Gato), ingestão de cebola (Cão/Gato) ou alho (Cão), ingestão de propilenoglicol (Gato) e de zinco (Cão). Estão ainda descritas outras causas de aparecimento de corpos de Heinz, tais como hipertiroidismo, linfoma, diabetes mellitus, administração de benzocaína, fenazopiridina, azul de metileno ou vitamina K.
Laboratório interno ou laboratório de referência.
O envio de amostras para análise a um laboratório de referência (LR) é comparável ao já habitual envio de casos clínicos a hospitais/centros de referência ou médicos veterinários (MV) que desenvolvem ou concentram a sua actividade profissional em determinadas áreas da medicina veterinária, por ex: a cardiologia ou a neurologia. Geralmente essa decisão prende-se com a formação específica que os clínicos desenvolveram na área referenciada, a sua maior experiência que advém de um maior volume de casos, associado à disponibilidade de equipamentos mais sofisticados, nem sempre ao alcance de qualquer CAMV. Ora esta ideia aplica-se facilmente aos LR que integram nas suas equipas profissionais dedicados exclusivamente à patologia clínica; que possuem maior experiência relacionada com o volume de casos/análises; e que têm à sua disposição equipamentos mais sofisticados do que os habitualmente disponíveis nos laboratórios dos CAMV.
Diagnóstico serológico de Leishmaniose por ELISA.
O diagnóstico da leishmaniose deve incluir não só a avaliação clínica como testes laboratoriais específicos (1). Os testes para diagnóstico de leishmaniose em cães mais correntemente usados na prática clínica incluem a citologia (de medula óssea, gânglio linfático, baço ou pele), a serologia - ELISA (Enzyme-Linked Immunosorbent Assay), IFI (Imunofluorescência Indirecta) e imunocromatografia (testes rápidos) - ou PCR (polymerase chain reaction). Qualquer que seja o teste utilizado é fundamental conhecer o tipo de método em causa para uma correcta interpretação dos resultados.
Hipo ou Hipertiroidismo?
A função da glândula tiroide é tipicamente avaliada pela medição da concentração dos níveis séricos das suas hormonas. Avaliar a capacidade de resposta da glândula tiroide à sua estimulação (p. ex. Teste de Estimulação com TSH) é considerado o teste gold standard no diagnóstico definitivo de disfunção tiroidea, contudo é raramente realizado na prática clínica devido aos elevados custos da TSH recombinante. Desta forma estão disponíveis testes que incluem a medição de T4, T4 livre (fT4), T3 livre (fT3) e 3,3’,5’triiodotironina (rT3), bem como a medição da concentração de TSH (1-7).
Novo método diagnóstico do Tétano.
O tétano é uma doença infeciosa causada por uma neurotoxina, formada durante o crescimento vegetativo da bactéria Clostridium tetani, que é um bacilo gram positivo, flagelado, não encapsulado, anaeróbio e produtor de esporos que podem sobreviver durante meses a anos.
Tumores caninos mais frequentes.
O cancro é uma doença comum em cães e representa uma das principais causas de mortalidade canina. Animais sem raça definida e de raça pura podem ser afetados (Komazawa et al., 2016). Embora a etiologia da maioria dos tumores seja provavelmente de origem multifatorial, algumas raças de cães com pedigree aparentam ter um maior risco para determinado tipo de tumores (Dobson, 2013; Grüntzig et al., 2016). Neste trabalho, o nosso objetivo foi determinar quais os tumores mais frequentes nas diferentes raças de cães existentes em Portugal.
Diagnóstico serológico de Leishmaniose por ELISA.
O diagnóstico da leishmaniose deve incluir não só a avaliação clínica como testes laboratoriais específicos (1). Os testes para diagnóstico de leishmaniose em cães mais correntemente usados na prática clínica incluem a citologia (de medula óssea, gânglio linfático, baço ou pele), a serologia - ELISA (Enzyme-Linked Immunosorbent Assay), IFI (Imunofluorescência Indirecta) e imunocromatografia (testes rápidos) - ou PCR (polymerase chain reaction). Qualquer que seja o teste utilizado é fundamental conhecer o tipo de método em causa para uma correcta interpretação dos resultados.
Otite externa: uma colheita adequada é fundamental para o diagnóstico.
A otite externa é uma das queixas mais comuns nas consultas de cães e gatos. Há numerosos agentes envolvidos tais como fungos (Malassezia pachydermatis), ácaros (Octodectes cynotis) e bactérias (Staphylococcus spp., Proteus spp. Pseudomonas spp., Escherichia coli).1 No caso dos ácaros estes podem atuar com agentes primários na otite externa enquanto os fungos e bactérias são geralmente considerados oportunistas e fatores perpetuadores na patogénese da otite.1 Nas causas primárias, para além dos ácaros, incluem-se por exemplo processos alérgicos e endocrinopatias que ao originarem reações inflamatórias levam à proliferação da microflora local.1
Categorização dos antibióticos para utilização em animais.
O surgimento e o aumento consistente de ocorrências de bactérias resistentes a múltiplos antibióticos são uma ameaça à saúde pública global. Tendo em vista a redução de bactérias resistentes que possam ser transferidas a humanos quer pela via da cadeia alimentar ou quer pelo contacto directo, a Agência Europeia de Medicamentos (EMA), através do AMEG (Antimicrobial Advice Ad Hoc Expert Group), publicou no início de 2020 um documento onde é efectuada a categorização dos antibióticos para utilização em animais com vista a um uso prudente e responsável.
Infeções do trato urinário em pequenos animais.
As infeções do trato urinário (ITU) são comuns em Medicina Veterinária, particularmente em canídeos. O seu diagnóstico é feito com base na história clínica (história de polaquiúria, estrangúria, disúria, hematúria, micção inadequada, ou periuria), exame físico, urianálise e cultura urinária. A cultura microbiológica combinada com os testes de sensibilidade é a melhor ferramenta para o diagnóstico e tratamento das ITU [1–4].
Padrões de resistência antimicrobiana de bactérias isoladas.
A otite externa é uma das doenças mais comuns em animais de companhia, em particular nos cães [1]. O seu diagnóstico é feito com base na história do animal, exame otoscópico da membrana timpânica e sinais clínicos como eritema, edema, odor fétido e prurido. É uma doença de etiologia multifatorial, sendo as leveduras e bactérias a principal etiologia [2,3]. Citologia, cultura microbiológica e testes de suscetibilidade antibacteriana são necessários para um correto diagnóstico e tratamento.